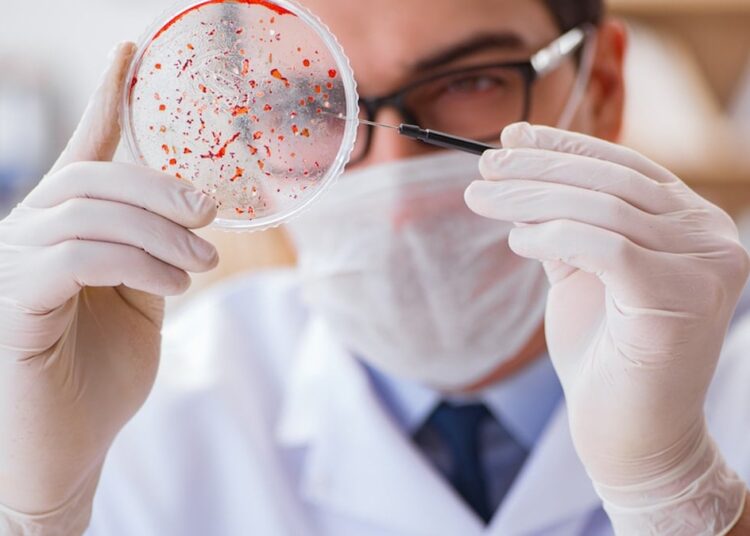
Kanser tedavisinde yeni umut: Kemoterapi olmadan tam düzgünleşme gerçekleşti

Bağışıklık sisteminin doğal “katil hücreleri” (NK hücreleri) üzerinden kanserle çabayı hedefleyen QUILT-106 isimli klinik çalışmanın sonuçları açıklandı. ABD’li araştırma firması ImmunityBio tarafından yürütülen çalışmada, az görülen bir kan kanseri çeşidi olan Waldenström Makroglobulinemisi (lenfoplazmasitik lenfoma) hastalarında kemoterapi uygulanmadan düzgünleşme sağlandığı bildirildi. Klasik tedavilere karşılık vermeyen ve tedavisi “imkansız” olarak bedellendirilen hastalarda elde edilen sonuçlar dikkat çekti.
DÖRT DOZDA TAM İYİLEŞME
Çalışmada, “CD19 CAR-NK” hücre terapisi ile “Rituximab” isimli ilacın kombinasyonu küçük bir hasta kümesine uygulandı.
Tedavi gören iki hastada hastalığın büsbütün ortadan kalktığı, tedavinin kesilmesinden sonra yapılan 7 ve 15 aylık takiplerde rastgele bir belirtiye rastlanmadığı belirtildi.
Özellikle kemik iliğinin yüzde 95’i tümörle kaplı olan ve standart tedavilerin başarısız olduğu bir hastada, sırf dört doz sonrasında tam güzelleşme gözlenmesi öne çıkan bulgular ortasında yer aldı.
TEDAVİYE KARŞILIK VERMİYORDU
Araştırmada, standart tedavilere karşılık vermeyen dört hastanın tamamında hastalığın denetim altına alındığı tabir edildi.
ImmunityBio’nun kurucusu Dr. Patrick Soon-Shiong, bu sonucun bağışıklık sistemini tekrar aktive ederek kanseri denetim altına alma yaklaşımını doğruladığını söyledi. Soon-Shiong, hiçbir seçeneği kalmamış hastalarda tedavi bittikten bir yıl sonra bile güzelleşmenin sürdüğünü görmenin, bu az hastalık için manalı bir ilerleme olduğunu vurguladı.
HASTANEYE YATIŞ GEREKTİRMİYOR
Yeni CAR-NK yaklaşımı, klasik CAR-T hücre tedavilerinden birtakım taraflarıyla ayrılıyor. Hastanın kendi hücrelerinin haftalarca laboratuvarda işlenmesine gerek kalmadan, daha süratli uygulanabilen bir hücre sınırı kullanılıyor.

Tedavinin hastaneye yatış gerektirmeden ayakta uygulanabildiği ve şimdiye kadar önemli bir yan tesir gözlenmediği bilgisi paylaşıldı.
TESTLER DEVAM EDECEK
Tedavinin temelinde bedende doğal olarak bulunan NK hücrelerinin genetik olarak modifiye edilmesi yer alıyor.
Bu hücrelere, kanser hücrelerinin üzerindeki CD19 proteinini tanıyan CD19-CAR alıcısı ile bağışıklık sisteminin antikorlarla iş birliğini sağlayan CD16 alıcısı ekleniyor.
Böylece modifiye edilmiş NK hücreleri, kanserli hücreleri daha kolay tespit ederek yok edebiliyor. Rituximab ilacının eklenmesiyle bu atağın daha da güçlendiği belirtiliyor.
Bulguların Amerikan Hematoloji Derneği’nin yıllık toplantısında sunulacağı açıklanırken, Waldenström makroglobulinemisinin ekseriyetle iyileşemeyen kronik bir kanser çeşidi olduğu hatırlatıldı. Şirket, elde edilen olumlu sonuçların akabinde tedaviyi daha geniş bir hasta kümesinde test etmek için çalışmalarını sürdüreceğini duyurdu.
Kaynak: Sözcü